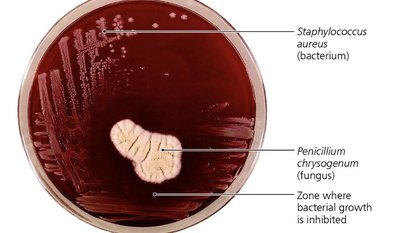
Penicillium chrysogenum inhibiting Staphylococcus aureus

BackChapter 10 Controlling Microbial Growth
Study Guide - Smart Notes
Tailored notes based on your materials, expanded with key definitions, examples, and context.
Controlling Microbial Growth in the Body: Antimicrobial Drugs
The History of Antimicrobial Agents
Antimicrobial agents are drugs used to treat infections by selectively targeting pathogens while minimizing harm to the host. The development of these agents revolutionized medicine, enabling effective treatment of bacterial, fungal, and some viral diseases.
Drugs: Chemicals that affect physiology in any manner.
Chemotherapeutic agents: Drugs that act against diseases, including infections and cancer.
Antimicrobial agents: Drugs specifically used to treat infections.
Key historical figures:
Paul Ehrlich: Proposed "magic bullets"—drugs that selectively kill pathogens. Developed arsenic compounds for microbial control.
Alexander Fleming: Discovered penicillin from Penicillium fungus.
Gerhard Domagk: Discovered sulfanilamide, the first widely used antibiotic.
Selman Waksman: Discovered streptomycin and other antibiotics from soil organisms.
Semisynthetics: Chemically modified antibiotics for improved efficacy, stability, and absorption (e.g., doxycycline).
Synthetics: Completely synthesized antimicrobials (e.g., sulfonamides, cephalosporins).
Example: Penicillin released from Penicillium chrysogenum inhibits bacterial growth, as seen in the clear zone around the fungus.
Sources of Common Antibiotics
Antibiotics are derived from various microorganisms, primarily bacteria and fungi. Most antibiotics used clinically originate from bacterial sources.
Microorganism | Antimicrobial |
|---|---|
Penicillium chrysogenum (Fungi) | Penicillin G |
Penicillium griseofulvum (Fungi) | Griseofulvin |
Acremonium spp. (Fungi) | Cephalothin |
Amycolatopsis orientalis (Bacteria) | Vancomycin |
Bacillus licheniformis (Bacteria) | Bacitracin |
Streptomyces griseus (Bacteria) | Streptomycin |
Streptomyces aureofaciens (Bacteria) | Tetracycline |
Streptomyces nodosus (Bacteria) | Amphotericin B |
Streptomyces noursei (Bacteria) | Nystatin |
Streptomyces avermitilis (Bacteria) | Ivermectin |

Additional info: Most antibiotics are produced by bacteria, especially the genus Streptomyces.
Mechanisms of Antimicrobial Action
Antimicrobial drugs act by targeting specific structures or processes in pathogens. Successful chemotherapy requires selective toxicity—drugs must harm pathogens more than the host.
Antibacterial drugs: Largest group due to unique bacterial targets.
Antifungal and antiparasitic drugs: Fewer options due to similarities with human cells.
Antiviral drugs: Limited because viruses rely on host cell machinery.

Key mechanisms:
Inhibition of cell wall synthesis
Inhibition of protein synthesis
Disruption of cytoplasmic membranes
Inhibition of metabolic pathways
Inhibition of nucleic acid synthesis
Prevention of virus attachment, entry, or uncoating
Inhibition of Cell Wall Synthesis
Drugs targeting cell wall synthesis are highly effective against bacteria, as mammalian cells lack cell walls. Most agents prevent cross-linkage of peptidoglycan subunits (NAM and NAG).
Beta-lactams: Bind to enzymes that cross-link NAM subunits, weakening cell walls and causing lysis.
Semisynthetic beta-lactams: Modified for stability, absorption, and broader activity.
Vancomycin and cycloserine: Interfere with bridges linking NAM subunits in Gram-positive bacteria.
Bacitracin: Blocks transport of NAG and NAM from cytoplasm.
Isoniazid and ethambutol: Disrupt mycolic acid formation in mycobacteria (e.g., Mycobacterium tuberculosis).
Echinocandins: Inhibit fungal cell wall synthesis by blocking glucan formation.

Additional info: These drugs are only effective against actively growing cells, as they do not affect existing peptidoglycan.
Inhibition of Protein Synthesis
Protein synthesis inhibitors exploit differences between prokaryotic (70S) and eukaryotic (80S) ribosomes, allowing selective targeting of bacterial translation.
Prokaryotic ribosomes: 70S (30S and 50S subunits)
Eukaryotic ribosomes: 80S (40S and 60S subunits)
Drugs: Aminoglycosides, tetracyclines, macrolides, chloramphenicol, antisense nucleic acids

Example: Oxazolidinone inhibits initiation of translation; antisense nucleic acids bind mRNA to block translation.
Disruption of Cytoplasmic Membranes
Some drugs compromise membrane integrity, leading to cell death. Fungal membranes contain ergosterol, a target for antifungal agents.
Nystatin and amphotericin B: Bind ergosterol, forming pores in fungal membranes.
Polymyxin: Disrupts Gram-negative bacterial membranes; toxic to human kidneys.
Anti-parasitic drugs: Target protozoan membranes.

Additional info: Bacteria lack sterols, so these drugs are not effective against them.
Inhibition of Metabolic Pathways
Antimetabolic agents block unique pathways in pathogens, sparing host cells.
Atovaquone: Interferes with electron transport in protozoa and fungi.
Heavy metals: Inactivate enzymes.
Amantadine, rimantadine: Prevent viral uncoating.
Protease inhibitors: Block HIV replication.
Sulfonamides: Competitive inhibitors of PABA, blocking folic acid synthesis and nucleic acid production.

Example: Sulfonamides block folic acid synthesis, essential for DNA and RNA production in bacteria.
Inhibition of Nucleic Acid Synthesis
Drugs targeting nucleic acid synthesis block DNA replication or RNA transcription, often affecting both prokaryotic and eukaryotic cells.
Quinolones and fluoroquinolones: Inhibit prokaryotic DNA gyrase, preventing DNA replication.
Nucleotide/nucleoside analogs: Distort nucleic acid structure, blocking replication and transcription; used against viruses and cancer cells.
RNA polymerase inhibitors: Block transcription.
Reverse transcriptase inhibitors: Target HIV replication; humans lack reverse transcriptase.

Additional info: Nucleoside analogs are especially effective against rapidly dividing cells.
Prevention of Virus Attachment, Entry, or Uncoating
Drugs in this category block viral attachment to host cells or prevent uncoating, halting infection at an early stage.
Attachment antagonists: Block viral binding to host receptors (e.g., Pleconaril).
Uncoating inhibitors: Prevent release of viral genome (e.g., Arildone).

Clinical Considerations in Prescribing Antimicrobial Drugs
Choosing an antimicrobial agent involves evaluating its spectrum of action, effectiveness, administration route, safety, and potential for resistance.
Ideal agents: Readily available, inexpensive, stable, easy to administer, nontoxic, nonallergenic, and selectively toxic.
Spectrum of action: Narrow-spectrum drugs target few organisms; broad-spectrum drugs target many.
Secondary infections: Broad-spectrum drugs may disrupt normal flora, allowing opportunistic pathogens to colonize.
Drug | Prokaryotes | Eukaryotes | Viruses |
|---|---|---|---|
Isoniazid | Mycobacteria | ||
Penicillin | Gram-positive bacteria | ||
Streptomycin | Gram-negative bacteria | ||
Tetracycline | Broad (many bacteria) | ||
Sulfonamides | Broad (many bacteria) | ||
Azoles | Fungi | ||
Arildone | Viruses |

Additional info: Broad-spectrum drugs are more likely to cause secondary infections.
Effectiveness Testing
Several laboratory tests evaluate antimicrobial efficacy:
Diffusion susceptibility (Kirby-Bauer) test: Measures zone of inhibition around drug disks.
Minimum inhibitory concentration (MIC) test: Determines lowest drug concentration preventing growth.
Minimum bactericidal concentration (MBC) test: Identifies lowest concentration killing bacteria.

Example: The Etest combines aspects of Kirby-Bauer and MIC tests, providing a gradient of drug concentration.
Routes of Administration
Antimicrobials can be administered topically, orally, intramuscularly, or intravenously. The route affects drug concentration and distribution.
Oral: Self-administered, lowest concentration.
Intramuscular: Injection into muscle, moderate concentration.
Intravenous: Direct to bloodstream, highest concentration.

Additional info: Most drugs are given orally for convenience, despite lower concentrations.
Safety and Side Effects
Adverse effects may include toxicity, allergies, and disruption of normal microbiota.
Toxicity: Drugs may harm kidneys, liver, or nerves; special care for pregnant women.
Therapeutic index (TI): Ratio of tolerated dose to effective dose; higher TI means safer drug.
Therapeutic window: Range of effective concentrations without excessive toxicity.
Disruption of microbiota: May cause secondary infections (e.g., yeast infections, post-viral pneumonia).
Allergies: Rare but can cause anaphylaxis; epinephrine (EpiPen) used for severe reactions.

Resistance to Antimicrobial Drugs
Microbial resistance arises through mutations or acquisition of resistance genes (R plasmids). Resistant strains proliferate when sensitive cells are eliminated.
Mechanisms:
Enzyme production (e.g., beta-lactamases deactivate penicillin)
Prevent drug entry
Alter drug target
Efflux pumps expel drugs
Biofilm formation
Special proteins (e.g., MfpA in Mycobacterium tuberculosis)
Multiple resistance: Pathogens may resist several drugs, especially in hospital settings.
Cross resistance: Resistance to similar drugs due to structural similarities.

Additional info: Multiple-drug-resistant pathogens are a major concern in healthcare environments.
Retarding Resistance
Strategies to slow resistance include maintaining high drug concentrations, using drug combinations, limiting unnecessary use, and developing new drug variants.
Synergism: One drug enhances another's effect.
Antagonism: Drugs interfere with each other.
Complete full course: Prevents survival of resistant cells.
Second/third-generation drugs: Modified to overcome resistance.

Example: Combination therapy can be more effective and reduce resistance development.